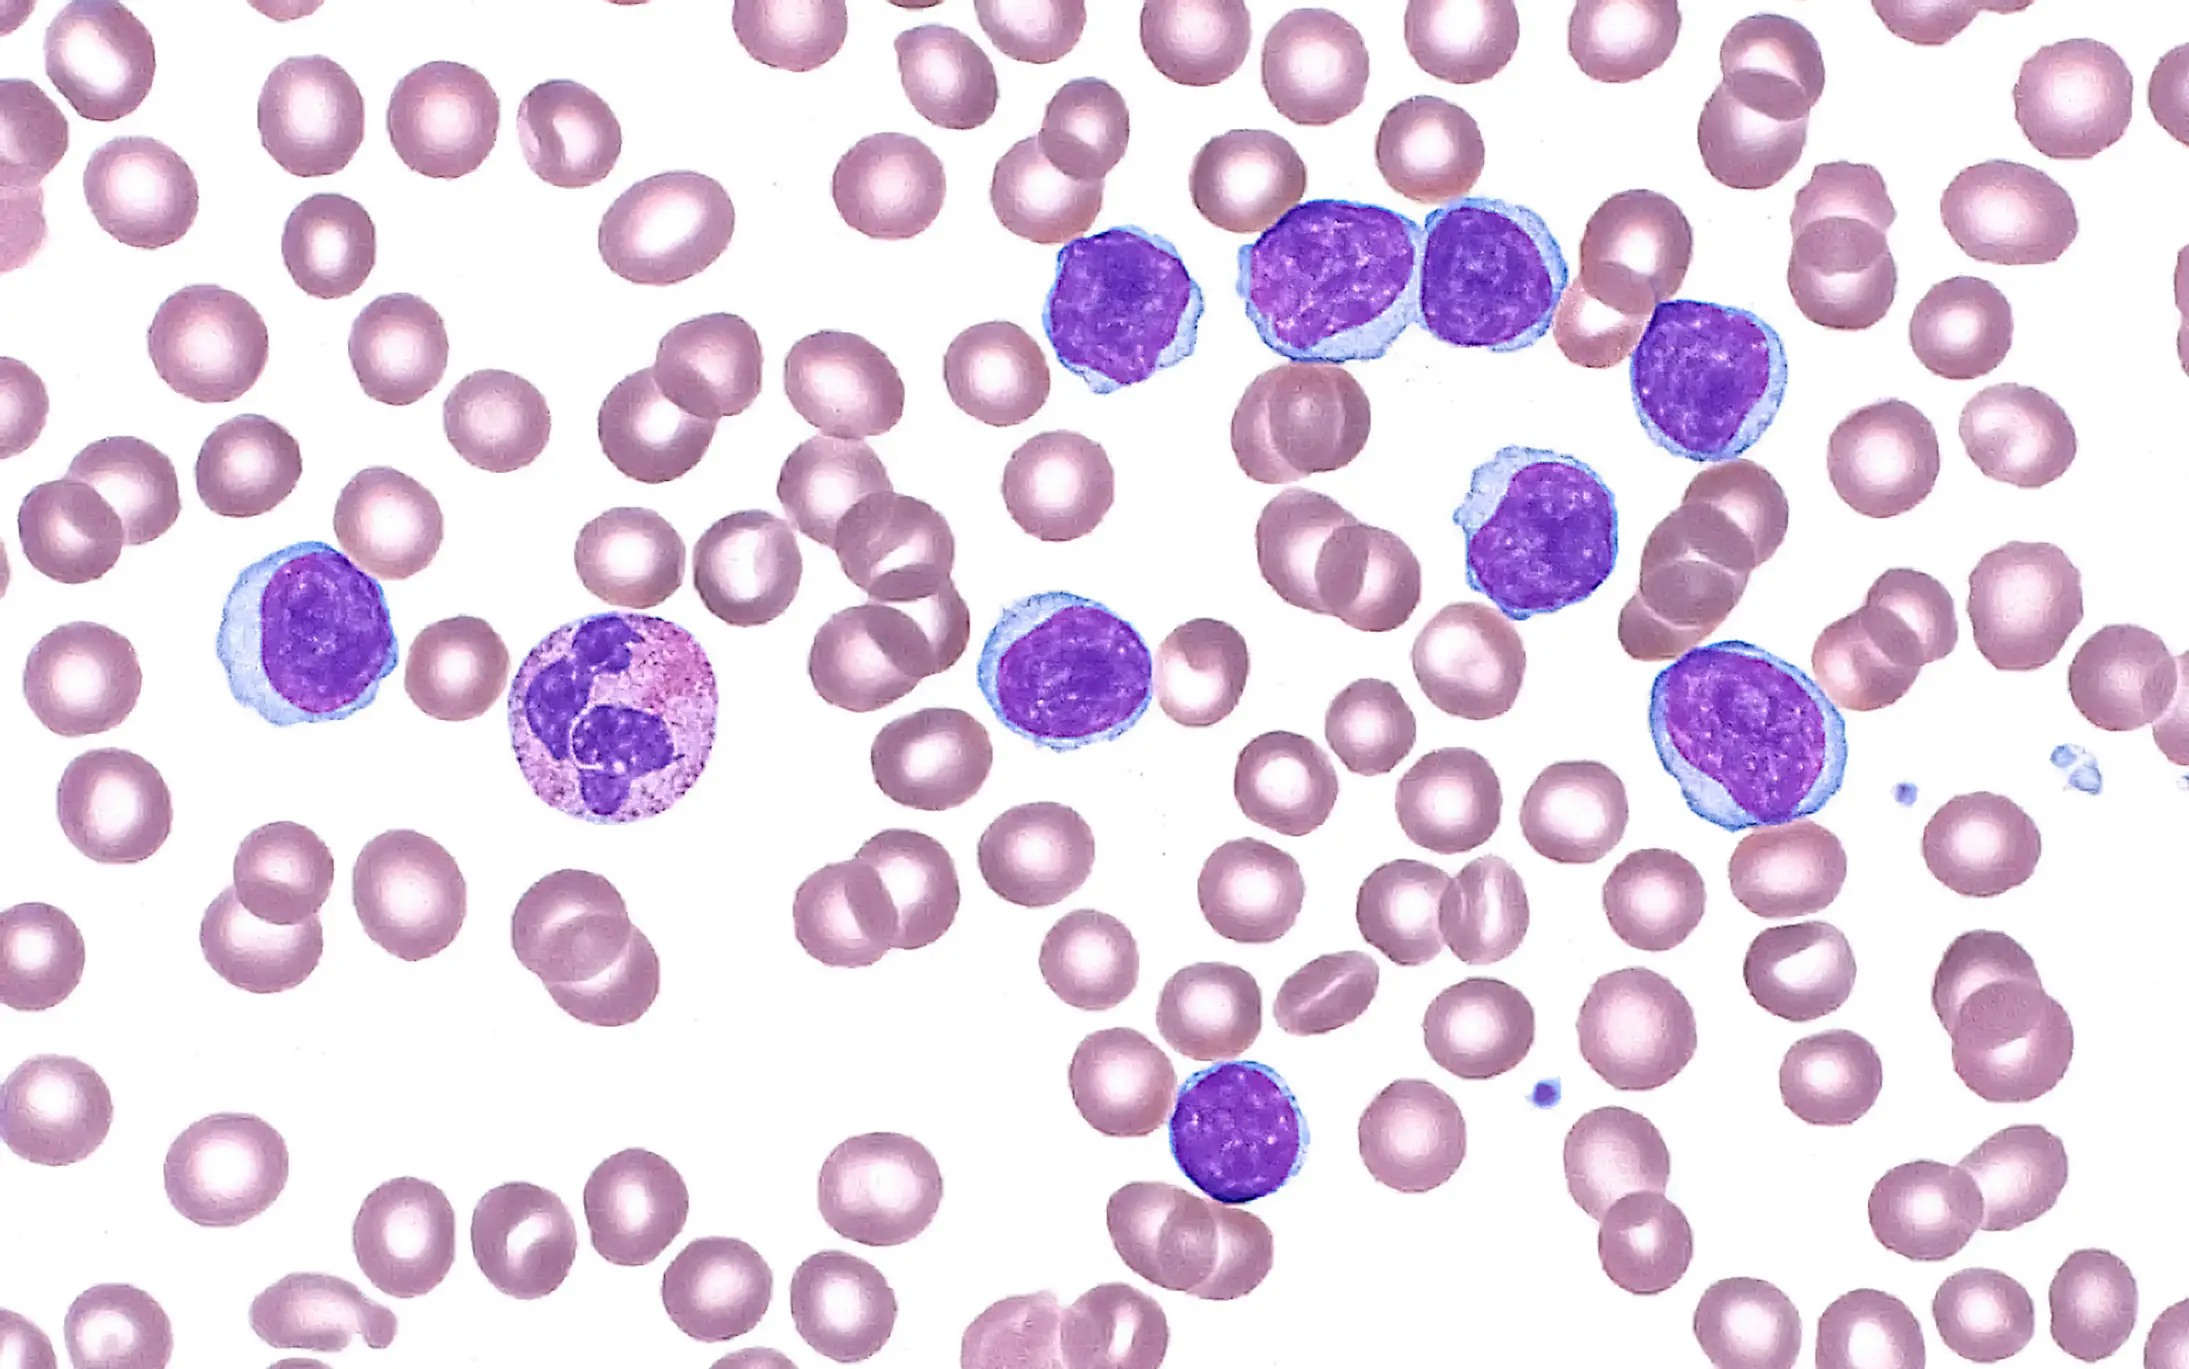
They found out she may have leukemia hours after she gave birth (ZIAD M. EL-ZAATARI/SCIENCE PHOTO LIBRARY)

Warning: This article contains discussion of cancer which some readers may find distressing.
Tatiana Schlossberg, the granddaughter of former President John F. Kennedy, has revealed her heartbreaking cancer diagnosis and what it was like to watch her cousin, RFK Jr., take up health politics.
Schlossberg announced in an essay published in The New Yorker on Saturday (November 22) that she had been given less than a year to live after being diagnosed shortly after giving birth to her second child in May 2024.
The 35-year-old revealed all on the 62nd anniversary of her grandfather's assassination, with the climate journalist also slamming her second cousin, Robert F Kennedy Jr., and his position as US health secretary under the Trump administration.
Advert
In her essay, Schlossberg said she was diagnosed with acute myeloid leukemia, which left her feeling confused.

The mother-of-two said she felt healthy, and in fact, she was the ‘healthiest’ person she knew.
Except, she wasn’t.
Despite her active lifestyle, which included running, skiing and ‘eerily’ swimming the New York's Hudson River ‘to raise money for the Leukemia and Lymphoma Society’, Schlossberg was the unfortunate victim of a mutated Leukemia that ‘liked to come back’, despite advanced and harsh treatments that left her with sores in her mouth and unable to eat.
Schlossberg wrote of the time that she found out about her diagnosis that ‘on May 25, 2024, my daughter was born at seven-oh-five in the morning, ten minutes after I arrived at Columbia-Presbyterian hospital, in New York’.
After she and her husband, urologist George Moran, admired their daughter, she said that a ‘few hours later, my doctor noticed that my blood count looked strange’.
Schlossberg explained that a ‘normal’ white-blood-cell count is ‘around four to eleven thousand cells per microlitre’, but hers was ‘a hundred and thirty-one thousand cells per microlitre’.
The doctor revealed it could be nothing more than something related to her pregnancy... or it could be cancer.
Sadly, despite her belief that it couldn’t be cancer as she felt fine, it was an aggressive form that would become terminal.
Despite a bone marrow transplant and chemotherapy, Schlossberg said doctors have explained she doesn’t have the best outcome.
"During the latest clinical trial, my doctor told me that he could keep me alive for a year, maybe," she wrote.
Schlossberg also described her sadness and nervousness at watching her second cousin, RFK Jr., become Donald Trump's health secretary.
"I watched from my hospital bed as Bobby, in the face of logic and common sense, was confirmed for the position, despite never having worked in medicine, public health, or the government," she shared in her open letter. "Suddenly, the healthcare system on which I relied felt strained, shaky."
The mom-of-two added: "Throughout my treatment, he had been on the national stage: previously a Democrat, he was running for president as an Independent, but mostly as an embarrassment to me and the rest of my immediate family."

Even though her family apparently tried to stop him from getting his role, it was no use, and he soon became known for his controversial health and medicine views.
Sadly, Schlossberg explained she knew she wouldn’t be around much longer to see what happens next in the world, but she vowed to try to ‘remember’ as much as possible to take with her into the next life.
UNILAD has reached out to Robert F. Kennedy Jr.'s office for comment.
If you’ve been affected by any of these issues and want to speak to someone in confidence, contact the American Cancer Society on 1-800-227-2345 or via their live chat feature, available 24/7 every day of the year.
Topics: Politics, US News, Robert F Kennedy Jr , John F. Kennedy, Cancer, Health
